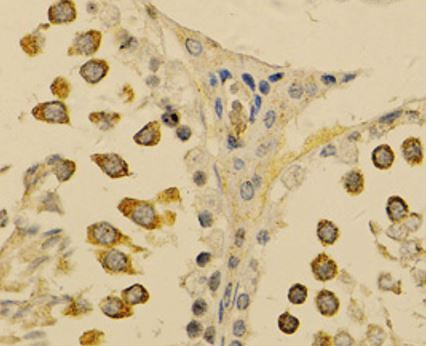
Anti-PIWIL2

Cookie preferences
This website uses cookies, which are necessary for the technical operation of the website and are always set. Other cookies, which increase the comfort when using this website, are used for direct advertising or to facilitate interaction with other websites and social networks, are only set with your consent.
Configuration
Technically required
These cookies are necessary for the basic functions of the shop.
"Allow all cookies" cookie
"Decline all cookies" cookie
CSRF token
Cookie preferences
Currency change
Customer-specific caching
FACT-Finder tracking
Individual prices
Selected shop
Session
Comfort functions
These cookies are used to make the shopping experience even more appealing, for example for the recognition of the visitor.
Note
Show the facebook fanpage in the right blod sidebar
Statistics & Tracking
Affiliate program
Conversion and usertracking via Google Tag Manager
Track device being used
| Item number | Size | Datasheet | Manual | SDS | Delivery time | Quantity | Price |
|---|---|---|---|---|---|---|---|
| ARG40555.100 | 100 µl | - | - |
6 - 14 business days* |
707.00€
|
If you have any questions, please use our Contact Form.
You can also order by e-mail: info@biomol.com
Larger quantity required? Request bulk
You can also order by e-mail: info@biomol.com
Larger quantity required? Request bulk
Protein function: Endoribonuclease that plays a central role during spermatogenesis by repressing... more
Product information "Anti-PIWIL2"
Protein function: Endoribonuclease that plays a central role during spermatogenesis by repressing transposable elements and preventing their mobilization, which is essential for the germline integrity (PubMed:11578866, PubMed:14736746, PubMed:17446352, PubMed:18381894, PubMed:18922463, PubMed:26669262). Plays an essential role in meiotic differentiation of spermatocytes, germ cell differentiation and in self-renewal of spermatogonial stem cells (PubMed:11578866, PubMed:14736746, PubMed:17446352, PubMed:18381894, PubMed:18922463, PubMed:26669262). Its presence in oocytes suggests that it may participate in similar functions during oogenesis in females (PubMed:11578866, PubMed:14736746, PubMed:17446352, PubMed:18381894, PubMed:18922463, PubMed:26669262). Acts via the piRNA metabolic process, which mediates the repression of transposable elements during meiosis by forming complexes composed of piRNAs and Piwi proteins and govern the methylation and subsequent repression of transposons (PubMed:11578866, PubMed:14736746, PubMed:17446352, PubMed:18381894, PubMed:18922463, PubMed:26669262). During piRNA biosynthesis, plays a key role in the piRNA amplification loop, also named ping-pong amplification cycle, by acting as a 'slicer- competent' piRNA endoribonuclease that cleaves primary piRNAs, which are then loaded onto 'slicer-incompetent' PIWIL4 (PubMed:22020280, PubMed:23706823, PubMed:26669262). PIWIL2 slicing produces a pre-miRNA intermediate, which is then processed in mature piRNAs, and as well as a 16 nucleotide by-product that is degraded (PubMed:28633017). Required for PIWIL4/MIWI2 nuclear localization and association with secondary piRNAs antisense (PubMed:18381894, PubMed:18922463, PubMed:26669262). Besides their function in transposable elements repression, piRNAs are probably involved in other processes during meiosis such as translation regulation (PubMed:19114715). Indirectly modulates expression of genes such as PDGFRB, SLC2A1, ITGA6, GJA7, THY1, CD9 and STRA8 (PubMed:16261612). [The UniProt Consortium]
| Keywords: | Anti-Piwi-like protein 2 |
| Supplier: | Arigo Biolaboratories |
| Supplier-Nr: | ARG40555 |
Properties
| Application: | IHC (paraffin), WB |
| Antibody Type: | Polyclonal |
| Conjugate: | No |
| Host: | Rabbit |
| Species reactivity: | mouse, rat |
| Immunogen: | Recombinant protein of Mouse PIWIL2 |
| MW: | 109 kD |
| Format: | Affinity Purified |
Database Information
| KEGG ID : | K02156 | Matching products |
| UniProt ID : | Q8CDG1 | Matching products |
| Gene ID : | GeneID 57746 | Matching products |
Handling & Safety
| Storage: | -20°C |
| Shipping: | +4°C (International: °C) |
Caution
Our products are for laboratory research use only: Not for administration to humans!
Our products are for laboratory research use only: Not for administration to humans!
Information about the product reference will follow.
more
You will get a certificate here
Viewed